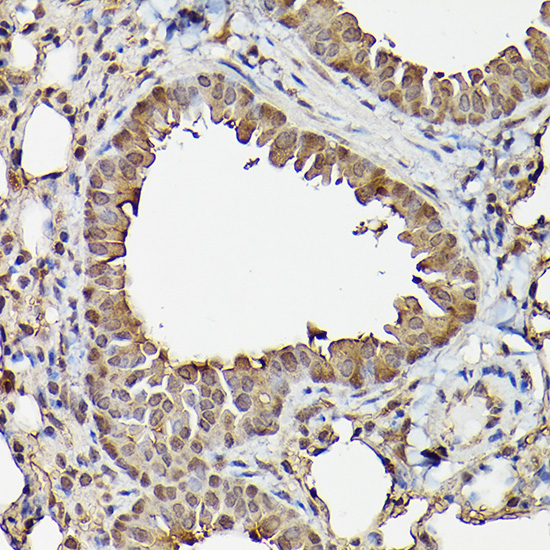

产品详情
产品名称NFkB-p65 Antibody
来源种属Rabbit
克隆性Polyclonal
纯化Antibodies were produced by immunizing rabbits with synthetic peptide and KLH conjugates. Antibodies were purified by affinity-chromatography using epitope-specific peptide.
应用WB;IHC;IF
种属反应性Human;Mouse;Rat
特异性The antibody detects endogenous level of total NFkB-p65 protein.
免疫原类型Peptide-KLH
免疫原描述Peptide sequence around aa.534~538 (F-S-S-I-A) derived from Human NFkB-p65.
基因/蛋白名称NFkB-p65
标记Unconjugated
别名NFKB3; RELA; TF65; Transcription factor p65; p65
数据库入口号Swiss-Prot: Q04206
NCBI Protein: NP_001138610.1
Uniprot
Q04206
浓度1.0mg/ml
配方Supplied at 1.0mg/mL in phosphate buffered saline (without Mg2+ and Ca2+), pH 7.4, 150mM NaCl, 0.02% sodium azide and 50% glycerol.
保存Store at -20°C for long term preservation (recommended). Store at 4°C for short term use.
应用详情
WB 1:500-1:2000; IHC 1:100-1:300; IF 1:50-1:500;
Western blot analysis of extracts from Hela and 293 cells using NFkB-p65 Antibody.
Western blot analysis of extracts from HT29, HL60 and COLO cells using NFkB-p65 Antibody.
Western blot analysis of extracts from NIH/3T3 and PC-12 cells using NF-kB p65 antibody.
Immunohistochemical analysis of paraffin-embedded human breast cancer using NFkB-p65 Antibody.
Immunohistochemical analysis of paraffin-embedded human placenta tissue using NFkB-p65 Antibody.
Immunohistochemistry of paraffin-embedded mouse lung using NF-kB p65 Rabbit pAb.
Immunofluorescence staining of PC-3 cells with NFkB-p65 Antibody at 1:200, counter-stained with DAPI.
Immunofluorescence analysis of PC-12 cells using NF-kB p65 Rabbit pAb at a dilution of 1:100 (40x lens).
Immunofluorescence analysis of C6 cells using NF-kB p65 Rabbit pAb.
NF-kappa-B is a pleiotropic transcription factor which is present in almost all cell types and is involved in many biological processed such as inflammation, immunity, differentiation, cell growth, tumorigenesis and apoptosis. NF-kappa-B is a homo- or heterodimeric complex formed by the Rel-like domain-containing proteins RELA/p65, RELB, NFKB1/p105, NFKB1/p50, REL and NFKB2/p52 and the heterodimeric p65-p50 complex appears to be most abundant one. The dimers bind at kappa-B sites in the DNA of their target genes and the individual dimers have distinct preferences for different kappa-B sites that they can bind with distinguishable affinity and specificity. Different dimer combinations act as transcriptional activators or repressors, respectively. NF-kappa-B is controlled by various mechanisms of post-translational modification and subcellular compartmentalization as well as by interactions with other cofactors or corepressors. NF-kappa-B complexes are held in the cytoplasm in an inactive state complexed with members of the NF-kappa-B inhibitor (I-kappa-B) family. In a conventional activation pathway, I-kappa-B is phosphorylated by I-kappa-B kinases (IKKs) in response to different activators, subsequently degraded thus liberating the active NF-kappa-B complex which translocates to the nucleus. NF-kappa-B heterodimeric p65-p50 and p65-c-Rel complexes are transcriptional activators. The NF-kappa-B p65-p65 complex appears to be involved in invasin-mediated activation of IL-8 expression. The inhibitory effect of I-kappa-B upon NF-kappa-B the cytoplasm is exerted primarily through the interaction with p65. p65 shows a weak DNA-binding site which could contribute directly to DNA binding in the NF-kappa-B complex
Doyle S L, et al. (2005) J Biol Chem. 280(25): 23496-23501.
Anwar K N, et al. (2004) J Immunol. 173(11): 6965-6972.
Baeuerle P A, et al. (1994) Annu Rev Immunol. 12:141-179.
Baeuerle P A, et al. (1996) Cell 87:13-20.
Haskill S, et al. (1991) Cell 65:1281-1289.
如果您使用该产品21014发表了文章,请通知我们,让我们可以引用您的文献。
et al,Prevention of acute kidney injury in a rodent model of cirrhosis following selective gut decontamination is associated with reduced renal TLR4 expression.
, (2012),
PMID:
22266601
et al,Artemether Activation of AMPK/GSK3β(ser9)/Nrf2 SignalIng Confers Neuroprotection towards β-Amyloid-Induced Neurotoxicity In 3xTg Alzheimer's Mouse Model. In Oxid Med Cell Longev on 2019 Nov 21 by Li S, Zhao X, et al..PMID:31871541
, (2019),
PMID:
31871541
et al,CYP4A11 is involved in the development of nonalcoholic fatty liver disease via ROS?induced lipid peroxidation and inflammation.In Int J Mol Med on 2020 Apr by Gao H, Cao Y, et al..PMID:32124935
, (2020),
PMID:
32124935
et al,Phytoestrogens protect joints in collagen induced arthritis by increasing IgG glycosylation and reducing osteoclast activation.In Int Immunopharmacol on 2020 Mar 12 by Du N, Song L, et al..PMID:32172207
, (2020),
PMID:
32172207
et al,Exendin-4 directly improves endothelial dysfunction in isolated aortas from obese rats through the cAMP or AMPK-eNOS pathways.In
Diabetes Res Clin Pract on 2012 Sep by Han L, Yu Y,et al..PMID:22560150
, (2012),
PMID:
22560150
et al,Dietary Oxidized n-3 PUFA Induce Oxidative Stress and Inflammation: Role of Intestinal Absorption of 4-HHE and Reactivity in Intestinal
Cells.In J Lipid Res on 2012 Oct by Manar Awada, Christophe O Soulage,et al..PMID:22865918
, (2012),
PMID:
22865918
et al,Role of toll鈥恖ike receptor 4 in mediating multiorgan dysfunction in mice with acetaminophen induced acute liver failure. In Liver Transpl on 2013 Jul by Maria Jover-Cobos, Ken-Ichi Tanamoto, et al..PMID:23554142
, (2013),
PMID:
23554142
查看更多
et al,Arctigenin suppresses renal interstitial fibrosis in a rat model of obstructive nephropathy.In Phytomedicine on 2017 Jul 1 by Ao Li , Xiaoxun Zhang,et al..PMID: 28545667
, (2017),
PMID: 28545667
et al,Endoplasmic reticulum stress participates in inflammation鈥恆ccelerated, lipid鈥恗ediated injury of human glomerular mesangial cells.In Nephrology (Carlton) on 2017 Mar by Haiping Yang, Jingjing Cui,et al..PMID: 26890338
, (2017),
PMID: 26890338
et al,Pteisolic acid G, a novel ent鈥慿aurane diterpenoid, inhibits viability and induces apoptosis in human colorectal carcinoma cells.In Oncol Lett on 2017 Nov by Shuangli Qiu ,Xin Wu,et al..PMID: 29113182
, (2017),
PMID: 29113182
et al, Neonatal chlorpyrifos exposure induces loss of dopaminergic neurons in young adult rats.In Toxicology on 2015 Oct 2 by Jie Zhang , Hongmei Dai et al..PMID: 26215101
, (2015),
PMID: 26215101
et al,Spautin-1 ameliorates acute pancreatitis via inhibiting impaired autophagy and alleviating calcium overload.In Mol Med on 2016 Oct by Juan Xiao , Xueping Feng et al..PMID:27579473
, (2016),
PMID: 27579473
et al,Protodioscin ameliorates fructose-induced renal injury via inhibition of the mitogen activated protein kinase pathway.In Phytomedicine on 2016 Nov 15 by Jinyang Shen, Xiaolin Yang et al..PMID:27765371
, (2016),
PMID: 27765371
et al,Loranthus Micranthus Extracts Suppress the Expression and Enzymatic Activity of Indoleamine 2, 3-Dioxygenase in Human Breast Cancer Cells via the Inhibition of JAK/STAT and NF-kB Pathways
, (2020),
PMID:
et al,5-HT2A Receptor and 5-HT Degradation Play a Crucial Role in Atherosclerosis by Modulating Macrophage Foam Cell Formation, Vascular Endothelial Cell Inflammation, and Hepatic Steatosis. In J Atheroscler Thromb on 2021 Feb 2 by Yingying Ma, Xiurui Liang,et al..PMID: 33536397
, (2021),
PMID: 33536397
et al,Alpha-lipoic acid alleviates NAFLD and triglyceride accumulation in liver via modulating hepatic NLRP3 inflammasome activation pathway in type 2 diabetic rats. In Food Sci Nutr on 2021 Mar 13 by Chih-Yuan Ko, Yangming Martin Lo, et al..PMID: 34026086
, (2021),
PMID: 34026086
et al,The A-to-I editing of KPC1 promotes intrahepatic cholangiocarcinoma by attenuating proteasomal processing of NF-κB1 p105 to p50. In J Exp Clin Cancer Res
on 2022 Dec 8 by Chengming Gao, Guangming Zhou, et al..PMID:36476255
, (2022),
PMID: 36476255
et al,The role of FTO in m6A RNA methylation and immune regulation in Staphylococcus aureus infection-related osteomyelitis.
, (2025),
PMID: 39980685
et al,Tiagabine protects dopaminergic neurons against neurotoxins by inhibiting microglial activation.In Sci Rep on 2015 Oct 26 by Jie Liu , Dongping Huang et al..PMID: 26499517
, (2015),
PMID: 26499517
et al,Peroxisome proliferator activated receptor alpha activation decreases inflammatory and destructive responses in osteoarthritic cartilage.
, (2011),
PMID: 21458577
et al,Platelet-Rich Plasma Releasate Inhibits Inflammatory Processes in Osteoarthritic Chondrocytes.
, (2011),
PMID: 21856929
et al,Pre-treatment of Human Umbilical Cord-Derived Mesenchymal Stem Cells With interleukin-6 Abolishes Their Growth-Promoting Effect on Gastric Cancer Cells.In Int J Mol Med on 2015 Feb by Mei Wang , Jie Cai et al..PMID:25483835
, (2015),
PMID: 25483835
et al,Cinnamaldehyde Inhibits Inflammation of Human Synoviocyte Cells Through Regulation of Jak/Stat Pathway and Ameliorates Collagen-Induced Arthritis in Rats. In J Pharmacol Exp Ther on 2020 May by Wen-Xiang Cheng, Shan Zhong, et al..PMID: 32029577
, (2020),
PMID: 32029577
et al,Visfatin Induces the Apoptosis of Endothelial Progenitor Cells via the Induction of Pro-Inflammatory Mediators Through the NF-魏B Pathway.Int J Mol Med on 2017 Sep by Lina Sun , Shuchun Chen et al..PMID: 28677720
, (2017),
PMID: 28677720
et al,Short鈥恡erm MyD88 inhibition ameliorates cardiac graft rejection and promotes donor鈥恠pecific hyporesponsiveness of skin grafts in mice.In Transpl Int on 2016 Aug by Wen-Tao He, Li-Min Zhang et al..PMID: 27125343
, (2016),
PMID: 27125343
et al,Nephrotoxicity induced by cisplatin is primarily due to the activation of the 5-hydroxytryptamine degradation system in proximal renal tubules
, (2021),
PMID:
et al,Differential apoptosis gene expressions of rhabdomyosarcoma cells in response to enterovirus 71 infection.In BMC Infect Dis on 2012 Nov 28 by Shi W, Li X,et al..PMID:23191987
, (2012),
PMID: 23191987
et al,Modified Xi-Jiao-Di-Huang Decoction Alleviates Sepsis via Regulating Macrophage Polarization by Inhibiting the PIM2/NF-κB Pathway
, (2025),
PMID: 40248592

有货
有货

